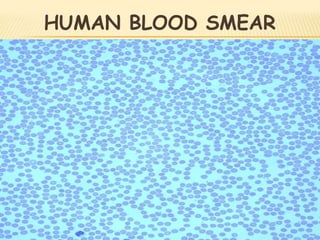
HUMAN BLOOD SMEAR
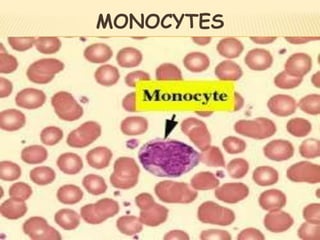
MONOCYTES

The document discusses the composition and functions of human blood. Blood is composed of plasma and formed elements such as red blood cells, white blood cells, and platelets. Red blood cells contain hemoglobin and transport oxygen throughout the body. White blood cells are part of the immune system and help fight infection. Platelets assist in blood clotting. Blood also regulates pH and temperature levels. The liver and kidneys help maintain proper blood composition.